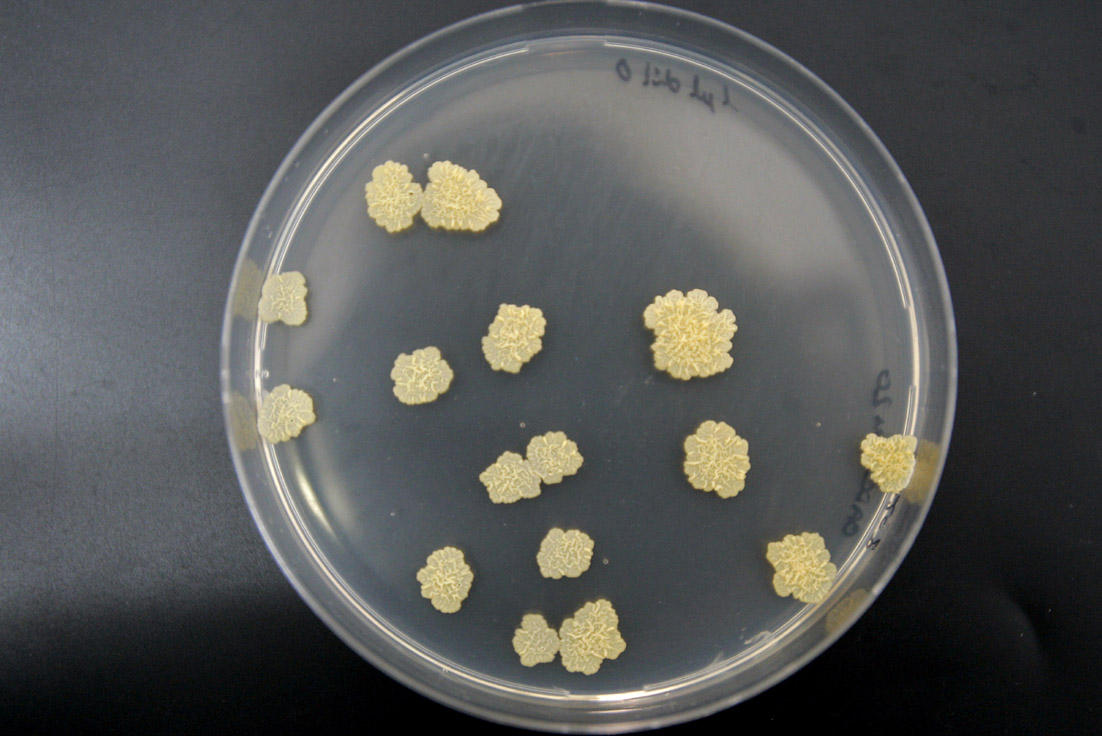

Посев на мбт
Shy guy minecraft
51 на карте псков
Время покажет 6 сентября 2025
Какой нибудь вкусное блюдо
Песня эйфории formula
Презентация на тему брат
Как снять с направляющих полку доводчиком
Tusa ucr 3125qb
Какие из указанных гипотез
Крутой папа на рутубе
Цитиколин для чего назначают простыми словами
Нлмк дивиденды 2025
Ирбисартан инструкция
Посев на мбт 113 фото